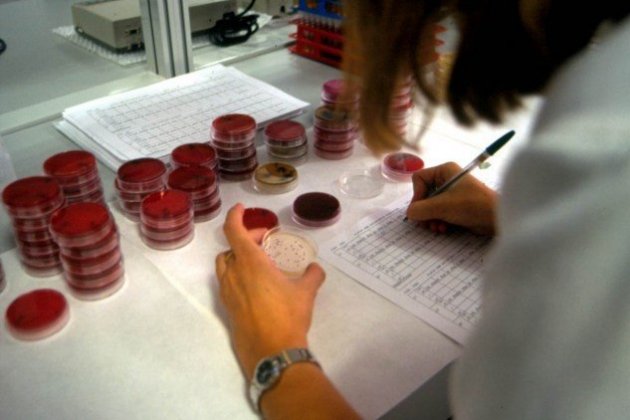
analisi micro

L’Agència Catalana de l’Aigua realitza el control de la qualitat de l’aigua a les zones de bany de Catalunya des del 1990 a través del Programa de vigilància i informació de l’estat de les platges. Durant 16 setmanes es fan mostrejos quinzenals a les platges i zones de bany continentals, cosa que suposa uns 2.000 controls analítics en cada temporada d’estiu.
Els controls i accions mediambientals de la Generalitat han permès millorar en 30 punts la salut de les costes catalanes

La xarxa de control de les zones de bany de la temporada 2019 està formada per 254 zones costaneres (87 al litoral de Girona, 83 al de Barcelona i 84 al de Tarragona) i 14 zones de bany interiors (7 a Lleida, 3 a Girona, 3 a Barcelona i 1 a Tarragona). La informació sobre la qualitat de les aigües de bany s’inicia l’1 de juny i finalitza el 24 de setembre, i es pot consultar al web de l’Agència i també a l’aplicació mòbil i web PlatgesCat.
Des dels inicis del Programa de vigilància el nombre de platges amb qualitat excel·lent s’ha incrementat des del 26% el 1990 fins a situar-se per sobre del 94% l’any 2018. Això suposa un increment de més de 30 punts, un fet que demostra que l’esforç que s’està fent al nostre país en matèria de sanejament per preservar les masses d’aigua, en aquest cas, les litorals, està donant resultats positius.
Platgescat
Des del 2014, l’Agència Catalana de l’Aigua disposa d’una aplicació, PlatgesCat, que informa en temps real de la qualitat de prop de 300 platges catalanes.
L’aplicació Platgescat permet conèixer l’estat del litoral a temps real

La qualitat de l’aigua, la temperatura, el temps, la bandera de seguretat, així com possibles incidències –com abocaments o presència de meduses– són alguns dels aspectes dels quals s’informa a través d’aquesta aplicació mòbil i web.

La depuració de l’aigua residual, un procés clau
La depuració de l’aigua residual és un procés clau per garantir la qualitat de l’aigua i, per tant, la salut de les persones i la preservació del medi. D’aquí la importància de retornar al medi (als rius i al mar) l’aigua que hem utilitzat, en condicions òptimes.
Gràcies a l’esforç en el sanejament i a l’acció coordinada de les administracions actuants han desaparegut els nombrosos punts negres (en termes de qualitat deficient) que Catalunya tenia fa 30 anys al litoral català, i molts rius han pogut recuperar la seva qualitat ambiental i tornar a ser rius vius arreu del país.
Les 521 estacions depuradores d’aigües residuals i els pretractaments que funcionen actualment a Catalunya garanteixen un adequat retorn al medi de les aigües prèviament utilitzades i eviten el deteriorament de les masses d’aigua, principi bàsic de la Directiva marc de l’aigua. Les depuradores en servei permeten tractar les aigües residuals del 97% de la població de Catalunya. La planificació hidrològica en l’àmbit del sanejament preveu seguir augmentant progressivament el percentatge de la població sanejada.
Catalunya multiplica per sis les seves depuradores en 30 anys
Durant la dècada dels anys 90 s’impulsa la construcció de nous sistemes de sanejament. Això permet, entre el període 1990-2000, doblar el número de població sanejada –dels 3 als 5 milions– i triplicar el nombre de depuradores existents (de 80 a 245 en 10 anys).
Entre 1990 i 2019, Catalunya passa de tenir 80 depuradores en servei a les 521 actuals, multiplicant la xifra per sis. El seu efecte en el medi és incontestable: es millora la qualitat de l’aigua i la seva transparència. Per una banda, les depuradores eviten l’abocament d’aigua sense tractar al medi i, per l’altra, aporten aigua a rius, rieres i mar en condicions prepotables. Això permet que, de manera lenta però progressiva, es millori la qualitat de les nostres masses d’aigua.

Les actuacions en matèria de sanejament no acaben aquí. La planificació hidrològica catalana preveu noves actuacions de sanejament, així com millores dels sistemes que estan en servei, que contribuiran a millorar encara més la qualitat de les nostres masses d’aigua.